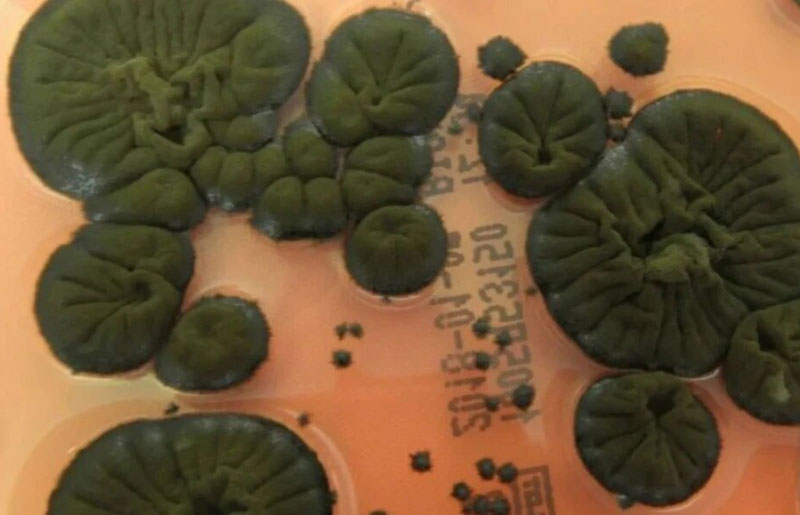
В Чернобыле нашли чёрный гриб, который растёт под воздействием радиации | Учёные изучают чернобыльский гриб, устойчивый к высоким уровням радиации

Новости России на сегодня
02 декабря 2025 в 13:46
02 декабря 2025
13 : 46
01 декабря 2025 в 19:28
01 декабря 2025
19 : 28
01 декабря 2025 в 18:03
01 декабря 2025
18 : 03
01 декабря 2025 в 14:30
01 декабря 2025
14 : 30
01 декабря 2025 в 14:05
01 декабря 2025
14 : 05
01 декабря 2025 в 13:00
01 декабря 2025
13 : 00
30 ноября 2025 в 20:00
30 ноября 2025
20 : 00
30 ноября 2025 в 17:02
30 ноября 2025
17 : 02
30 ноября 2025 в 08:11
30 ноября 2025
08 : 11
30 ноября 2025 в 00:20
30 ноября 2025
00 : 20
29 ноября 2025 в 15:02
29 ноября 2025
15 : 02
29 ноября 2025 в 14:07
29 ноября 2025
14 : 07
29 ноября 2025 в 13:15
29 ноября 2025
13 : 15
29 ноября 2025 в 12:49
29 ноября 2025
12 : 49
28 ноября 2025 в 14:01
28 ноября 2025
14 : 01
28 ноября 2025 в 13:30
28 ноября 2025
13 : 30
28 ноября 2025 в 12:55
28 ноября 2025
12 : 55
27 ноября 2025 в 12:29
27 ноября 2025
12 : 29
26 ноября 2025 в 10:50
26 ноября 2025
10 : 50